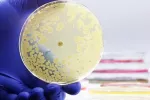

Decenas de fármacos no oncológicos pueden matar células cancerosas

22/01/2020
Una investigación en la que se han probado 4.518 compuestos del Centro de Reutilización de Medicamentos del Instituto Broad del MIT Massachusetts (Estados Unidos) sobre 578 líneas celulares de cáncer humano ha descubierto que 49 fármacos que actualmente se utilizan en el tratamiento de diferentes problemas de salud como diabetes, alcoholismo, inflamación, o incluso la artritis en los perros, tienen la capacidad de matar células cancerosas en el laboratorio.
Los resultados del estudio, que se han publicado en Nature Cancer, también han mostrado nuevos mecanismos de acción de estos medicamentos –como activar una proteína, o estabilizar la interacción entre proteínas– y dianas terapéuticas, que sugieren una posible vía para acelerar el desarrollo de nuevos fármacos oncológicos o la readaptación de algunos ya existentes para tratar el cáncer.
Muchos de los actuales medicamentos contra el cáncer actúan bloqueando proteínas, y han encontrado compuestos que pueden actuar mediante otros mecanismos
Sin embargo, en opinión del Dr. Ricardo Cubedo, responsable de la Unidad de Cáncer Hereditario del MD Anderson Cancer Center de Madrid, aunque se trata de "una idea muy interesante y provocativa, es una especie de vuelta al pasado en la búsqueda de fármacos al azar que tiene como ventaja, eso sí, que se trata de productos cuya toxicidad ya se conoce, así como las dosis e interacciones, mientras que una sustancia que está en la raíz de una planta habría que empezar por descartar que sea venenosa".
Y añade que "frente a lo que se hace ahora, que es diseñar fármacos con un objetivo conocido, no considero que investigar sobre este tipo de compuestos suponga una gran ventaja y, de hecho, no creo que de ahí vaya a salir ni un solo fármaco contra el cáncer. Lo que sí puede suceder es que se descubran nuevos mecanismos contra el cáncer que den lugar a nuevos fármacos de diseño; es decir, que se encuentre un nuevo talón de Aquiles de las células cancerosas que no se conocía, y se actúe con drogas de diseño sobre ese punto.
Nuevas formas de eliminar las células cancerosas
Los investigadores usaron una técnica de código de barras molecular que se conoce como PRIMS, desarrollada en el laboratorio Golub, con la que etiquetaron cada una de las líneas celulares con un código de barras de ADN, y esto les permitió asociar varias líneas celulares y realizar un experimento más amplio y de forma más rápida. El equipo expuso entonces cada grupo de células codificadas a uno de los compuestos que querían probar y midió la tasa de supervivencia de las células cancerosas.
Descubrieron así que algunos de estos compuestos eliminaban las células cancerosas de forma inesperada. El primer autor del estudio Steven Corsello, oncólogo en el Harvard and Dana-Farber Cancer Institute y miembro del laboratorio Golub, ha explicado que muchos de los medicamentos contra el cáncer disponibles actúan bloqueando proteínas, pero ellos han encontrado compuestos que pueden actuar mediante otros mecanismos.
"Se conoce la toxicidad del fármaco, pero no se sabe cómo funciona, y no se trata solo de ver si funciona, sino de comprobar si funciona mejor que otros que ya se utilizan"
Algunos de los fármacos que han identificado estos científicos parece que no actúan inhibiendo una proteína, sino activando una proteína o estabilizando la interacción entre estas. Muchos de estos medicamentos no oncológicos se activaron contra el tumor al interactuar con una diana molecular no reconocida previamente. Un ejemplo de ello es la tepoxalina, un fármaco antiinflamatorio originalmente destinado a las personas pero que se aprobó para tratar la osteoartritis en perros, y que eliminó las células tumorales al afectar a un objetivo desconocido en las células que sobreexpresan la proteína MDR1, que suele favorecer la resistencia a los medicamentos usados en quimioterapia.
Los investigadores también fueron capaces de predecir si determinados compuestos podrían eliminar cada línea celular observando las firmas genómicas de las líneas celulares, como las mutaciones y los niveles de metilación, que estaba incluidos en la base de datos de la Enciclopedia de la línea celular del cáncer (CCLE) del Instituto Broad. Y esto sugiere que estas firmas podrían emplearse algún día como biomarcadores para identificar a los pacientes que más se beneficiarían del tratamiento con ciertos fármacos.
Posibles aplicaciones de los hallazgos en el tratamiento del cáncer
Actualizado: 4 de mayo de 2023